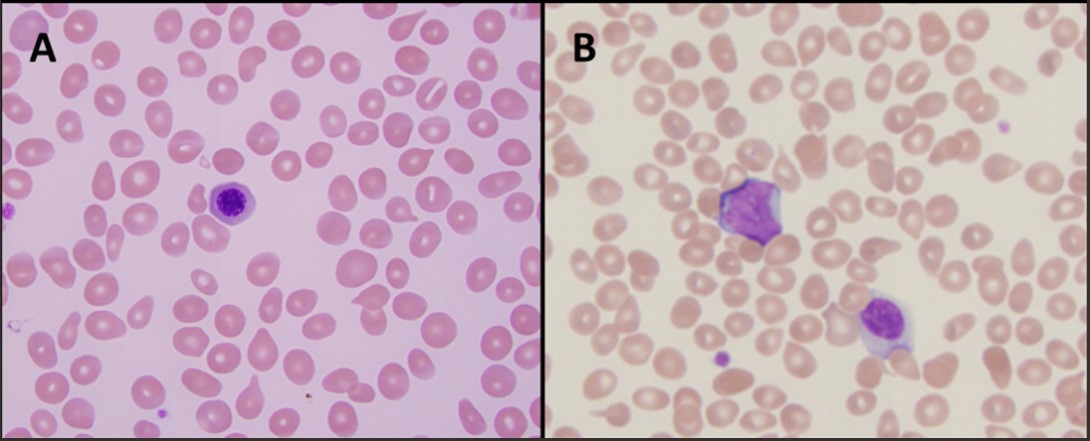

Tiarra Price, DO
@tiarraprice
Pathology PGY-2🔬 PCOM ‘23
ID: 1535088243745726473
10-06-2022 02:36:16
147 Tweet
503 Followers
297 Following









We are thrilled to present the new UPMC Pathology Residency Program 2025 Pathology PGY1 Residents! Welcome to UPMC Pathology, UPMC, and University of Pittsburgh. We wish you a productive and fulfilling journey during the four years (and hopefully more) City of Pittsburgh #Match2025 #MatchDay2025



More excellent presentations and posters for UPMC Pathology Residency Program trainees at #USCAP2025


UPMC Pathology Residency Program trainees Tiarra Price, DO, Rachel Centofanti, and Pranav Patwardhan presenting their oral and poster presentations at #USCAP2025





Great night at the Pirates game with some of the team! Happy to spend time outside of work with our awesome new PGY1s. Welcome to the crew! Haley Corbin


It's here! @matchtopath Annual Residency Application Bootcamp 🥳 When: Aug 25th - 29th RSVP by Aug 23rd to save your spot: linktr.ee/matchtopath Get ready for a week of webinars, breakout sessions, and mentorship. More details to come! #pathmatch26 Virtual Pathology Student Interest Group


🧺🔬 Pathology Residents and Fellows Picnic = Success! 🧺🔬 We traded microscopes for sunshine and enjoyed a fantastic day of food, games, and connection. Grateful for our amazing team UPMC Pathology Residency Program and the memories made! ☀️🍉🐶 #ResidentWellness



UPMC Pathology Residency Program invites all interested applicants to join our upcoming open houses! Learn why our residency is ranked among the top training programs in the country. First session: Wed, Aug 27, 6–7:30 pm EDT. Sign up here 👉 surveymonkey.com/r/UPMC_Patholo…